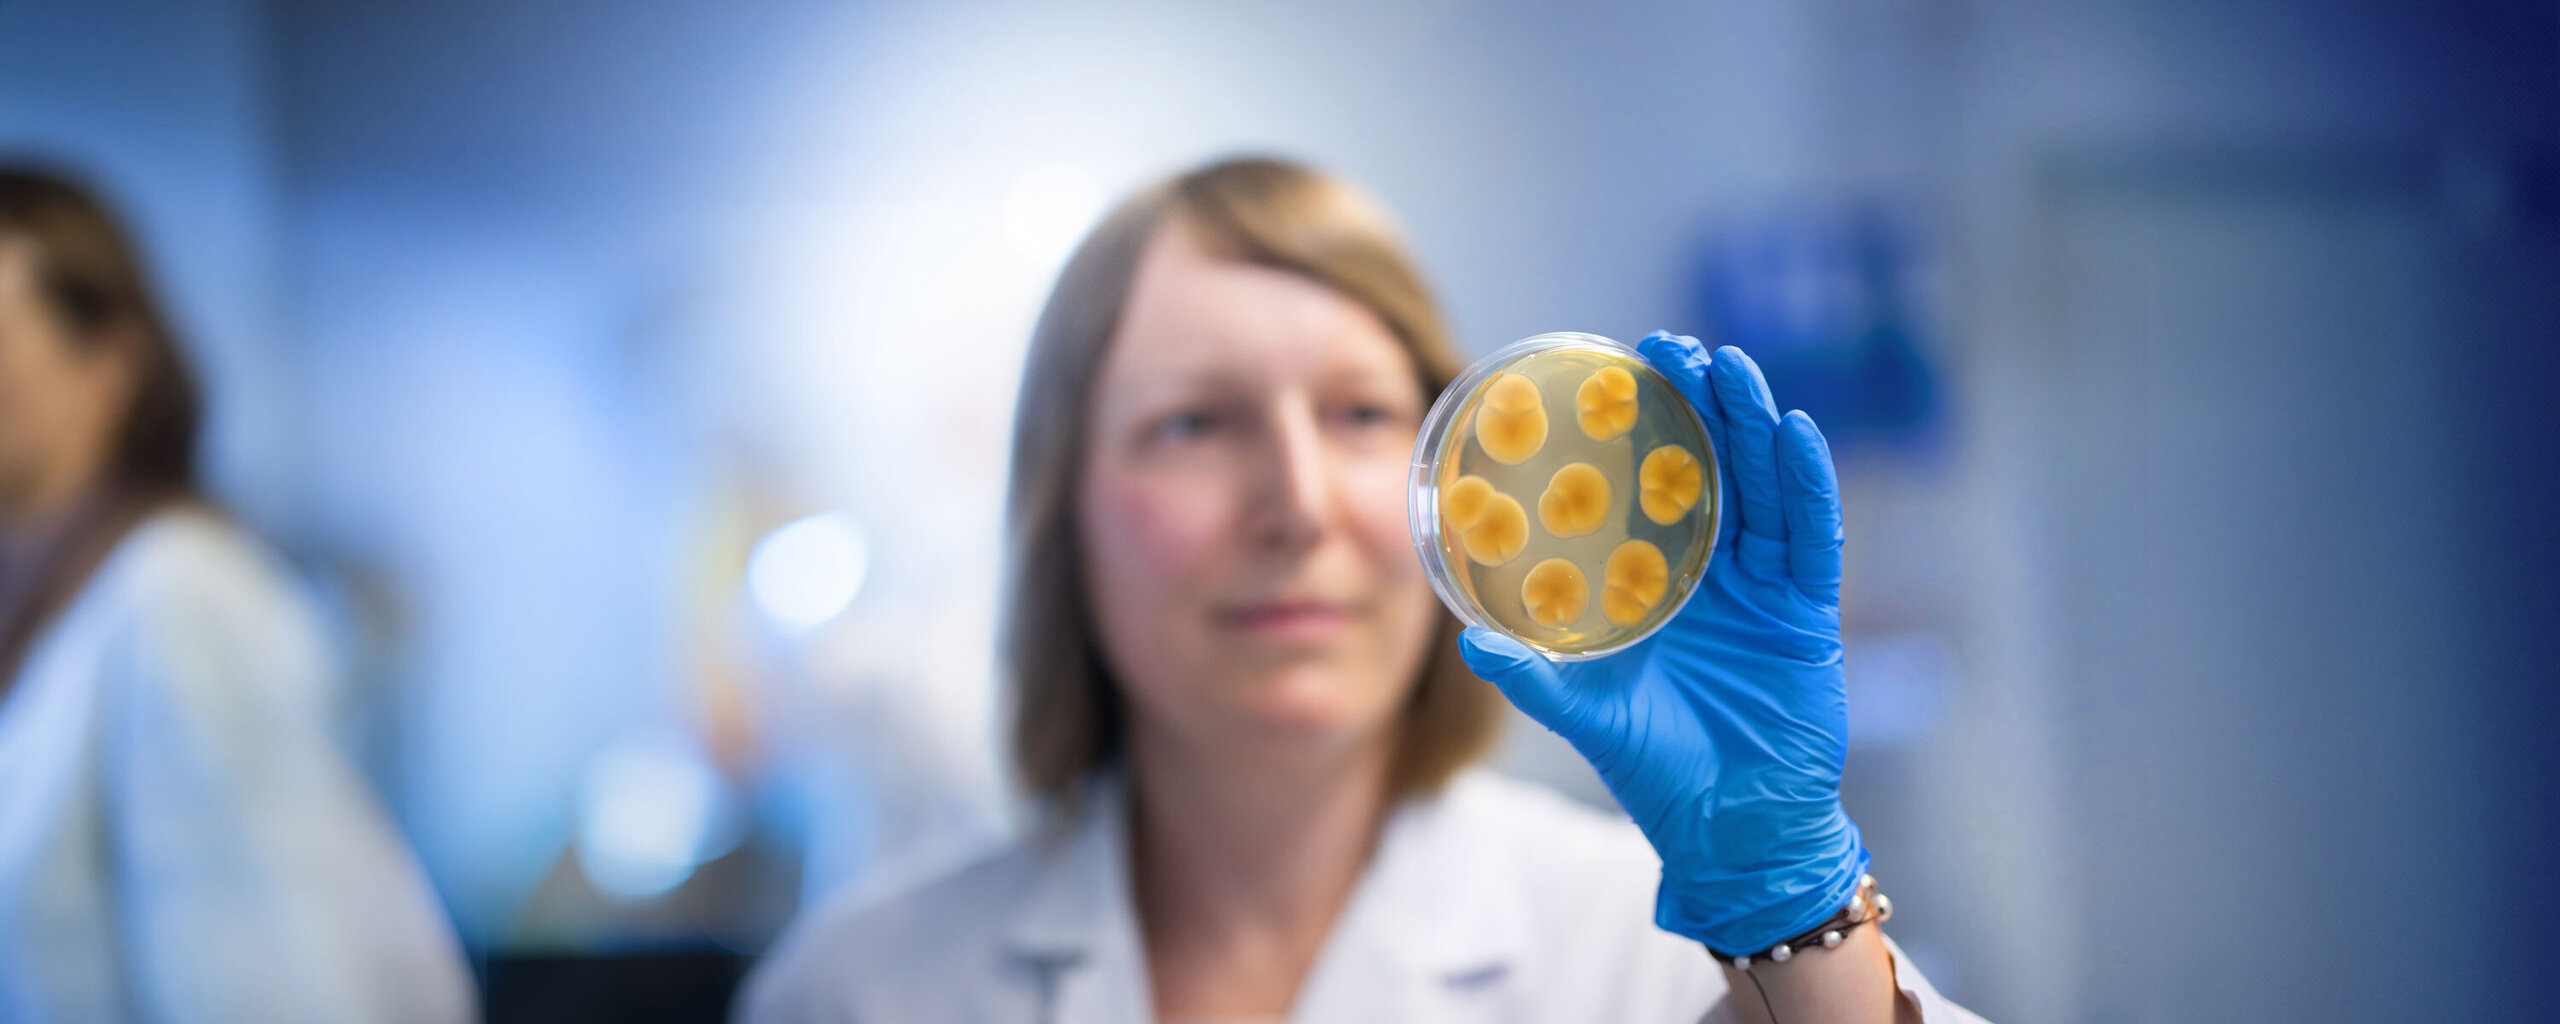
Die Labormitarbeiterin Maite Tresch begutachtet eine bewachsene Schimmelplatte

Die Labormitarbeiterin Maite Tresch begutachtet eine bewachsene Schimmelplatte
Als registrierter Kunde haben Sie mit einem persönlichen Online-Zugang jederzeit Zugriff auf Ihre Analysenergebnisse und können sich über den Bearbeitungsstand laufender Aufträge informieren.